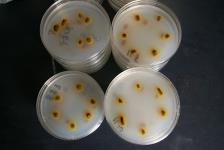

トップページ > しごと・産業 > 農林水産業 > 農業 > 農業総合研究センター > 農業総合研究センター > 過去の主な研究成果 > 大和高原地域の特産品開発・遺伝資源保存に関する過去の研究成果
印刷
ページ番号:7576
更新日:2026年2月27日
ここから本文です。
大和高原地域の特産品開発・遺伝資源保存に関する過去の研究成果
過去の主な研究成果
女性に優しい農業機械の開発
女性が農業で活躍する場を広げるため、操作が簡単で作業負担を軽減できる機械を県内企業と連携して開発しました。

汎用電動運搬車での除草作業

汎用電動運搬車への薬散機能の追加
大和野菜の機能性を向上させる生産技術の開発
県のチャレンジ品目として重点的に振興している大和野菜などにおいて、幅広い世代から注目されている機能性成分の向上を図る生産技術を開発しました。

イチゴの優良種苗供給
県内イチゴの安定生産のため、‘古都華’や‘アスカルビー’等の県育成の品種を中心に無病苗を増殖し、県優良親苗増殖協議会を通じて供給しています。
病原体の保有の有無を検定


病原体を保有しない苗を増殖
奈良に歴史的にゆかりのある遺伝資源の保存と活用
ジーンバンクでは、奈良にゆかりのある遺伝資源の種子を収集しています。収集した種子は、発芽率が低下しないように、専用の施設内で保存しています。また、実際に栽培を行い、遺伝資源のもつ特性を調査しています。
なお、配付可能な種子については、大和野菜研究センターHP(遺伝資源の配付について)に掲載しています。また、農研機構遺伝資源センター農業生物資源ジーンバンク植物遺伝資源の横断検索(https://www.gene.affrc.go.jp/databases-plant_cross_search.php)から検索できます。

収集した種子の保存施設内の様子

ジーンバンクに保存されている種子から栽培されたスイカ
春レタス跡の同じ畝・マルチを再利用した早生エダマメの省力栽培
東部山間地域では、春レタスのあとに早生エダマメが栽培されています。当センターではこの作型の省力化について取り組みました。春レタス収穫後の畝やマルチをそのまま再利用することで、早生エダマメ播種前の畝立て作業等を省略できます。
